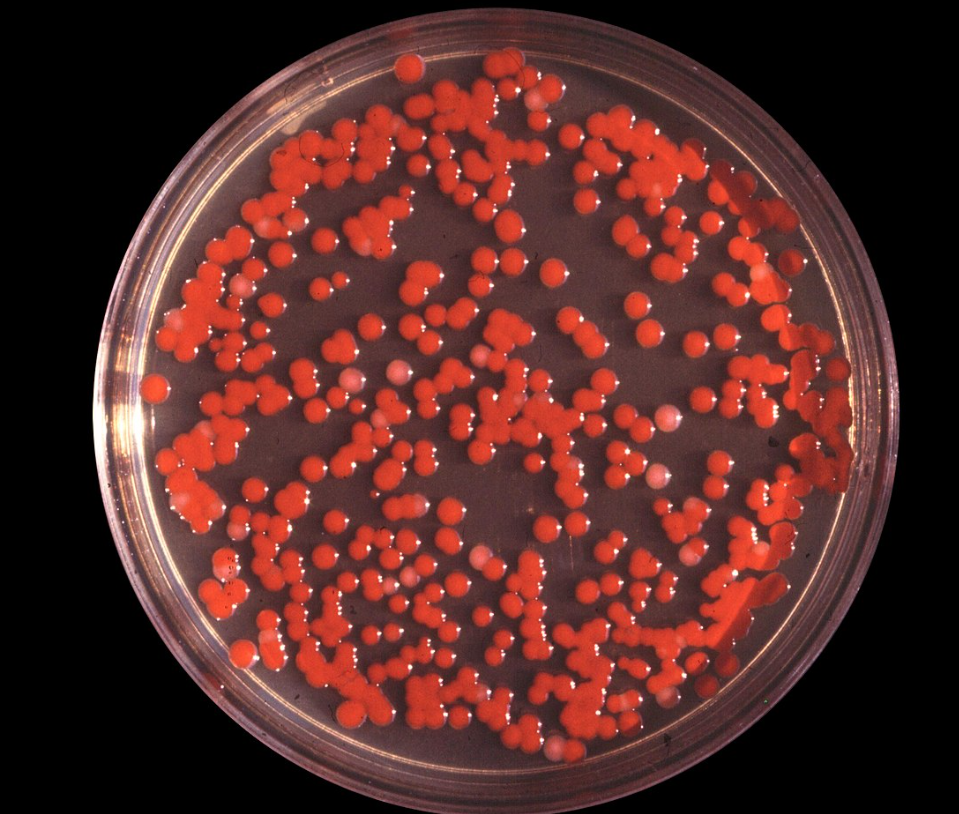
박테리아 세균.png

욕실 속 붉은 슬라임, 방치하면 병원 신세?!
면역 약한 사람에겐 위험! 화장실 속 세균 폭탄 제거법
아침에 부스스한 얼굴로 욕실에 들어갔다가, 변기나 세면대 주변에 퍼진 분홍빛 물질을 발견한 적이 있는가? 대수롭지 않게 넘길 수도 있지만, 사실 이 정체불명의 '붉은 슬라임'은 생각보다 우리의 건강에 위협이 될 수 있다. 단순한 물때가 아니라, 특정한 박테리아가 번식한 결과물이기 때문이다.
 화장실에 발생하는 세라티아 마르세센스 박테리아의 위험성
화장실에 발생하는 세라티아 마르세센스 박테리아의 위험성'붉은 슬라임'의 정체는?
많은 사람들이 이 분홍빛 물질을 단순한 곰팡이나 세제 잔여물로 오해하곤 한다. 하지만 이는 '세라티아 마르세센스(Serratia marcescens)'라는 박테리아의 일종이다. 이 박테리아는 욕실처럼 습하고 따뜻한 환경에서 쉽게 증식하며, 특히 비누나 샴푸의 잔여물을 영양원으로 삼아 성장한다. 따라서 청소를 자주 하지 않는 욕실에서는 쉽게 발견될 수 있다.
건강에 미치는 영향
보통 면역력이 정상적인 사람에게는 큰 해를 끼치지 않지만, 면역력이 약한 사람들에게는 감염의 위험이 있다. 영국 NHS 외과의사인 카란 라잔(Karan Rajan) 박사는 이 박테리아가 눈, 개방된 상처, 혹은 호흡기를 통해 체내로 들어가면 결막염, 요로 감염, 폐렴 등 다양한 감염을 유발할 수 있다고 경고했다. 특히 당뇨병 환자나 암 치료를 받고 있는 환자처럼 면역력이 약한 사람들은 이 박테리아에 감염될 경우 패혈증까지 이어질 위험이 있다.
 세라티아 마르세센스(Serratia marcescens)라는 박테리아의 잠재적 위험성을 경고하는 아흐메드 압드 엘바리 박사
세라티아 마르세센스(Serratia marcescens)라는 박테리아의 잠재적 위험성을 경고하는 아흐메드 압드 엘바리 박사 [사진 = 아흐메드 압드 엘바리(Ahmed Abd Elbary) 박사 틱톡]
[사진 = 아흐메드 압드 엘바리(Ahmed Abd Elbary) 박사 틱톡]단순한 오염이 아닌 감염의 위험
이 박테리아가 더 위험한 이유는 항생제 내성을 가질 가능성이 높기 때문이다. 2013년 국립의학도서관에 발표된 논문에 따르면, 병원 환경에서도 발견되는 이 균은 여러 항생제에 대한 복합 내성을 보이며, 감염 시 치료가 어려운 경우가 많다. 연세대학교 의과대학 내과학교실에서 발표한 연구에서도 이 박테리아에 감염될 경우 패혈증으로 이어질 가능성이 높다는 점을 지적했다.
 세라티아 마르세센스(Serratia marcescens)
세라티아 마르세센스(Serratia marcescens)어떻게 예방할 수 있을까?
다행히도 이 박테리아는 청소를 철저히 하면 쉽게 제거할 수 있다. 다만, 다시 생기는 것을 방지하려면 욕실을 항상 건조하게 유지하는 것이 중요하다.
▶정기적인 청소: 적어도 일주일에 한 번 이상 화장실을 청소해야 한다. 물때가 생긴 부위는 베이킹소다와 식초를 활용하거나, 치약을 이용해 닦아내면 효과적이다.
▶습기 제거: 샤워 후에는 반드시 창문을 열어 환기시키거나, 환풍기를 이용해 욕실 내부를 건조하게 유지해야 한다.
▶표백제 사용: 일반적인 세정제로는 완벽한 박테리아 제거가 어려울 수 있다. 미국 경제 전문지 포브스(Forbes)는 물과 표백제(10% 용액)를 섞어 사용하는 방법을 추천했다.
▶욕실 용품 관리: 오래된 샤워 커튼, 칫솔컵, 비누 받침 등은 주기적으로 교체하는 것이 좋다. 특히 칫솔컵은 물기가 남아 있어 박테리아가 번식하기 쉽기 때문에 자주 세척하는 것이 중요하다.
작은 습관이 건강을 지킨다
단순한 물때라고 생각하고 방치하면 예상치 못한 건강 문제를 초래할 수 있다. 특히 면역력이 약한 가족이 있다면 욕실 위생 관리에 더욱 신경을 써야 한다. 오늘부터라도 욕실 구석구석을 점검해 보고, 붉은 슬라임이 생기지 않도록 작은 습관부터 실천해 보자. 깨끗한 욕실이야말로 건강을 지키는 첫걸음이다.